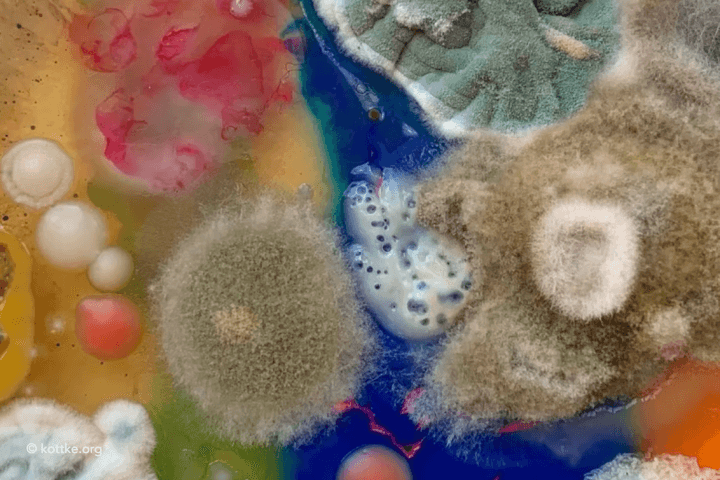
Is Mould To Blame For My Symptoms?

Written by: Jade Leighton
Written on: April 8, 2024
Feeling tired all the time? Prone to respiratory issues? Experiencing skin issues? Feeling itchy? Feeling anxious? Struggling with brain fog? Bloating a lot? Noticing a sensitivity to light? Suffering from headaches or migraines? Struggling with sleep? Experiencing dizziness or vertigo? These are all possible symptoms of mould illness.
Nutritional Therapist Jade Leighton shares her thoughts.
More and more clients are coming into my clinic with a myriad of strange symptoms like these that their doctors can’t explain. Even other nutritionists might not consider the very likely cause of these symptoms if they are too focused on diet, as it’s the built environment that predominantly harbours mould and its mycotoxins in levels high enough to drive serious illness. At this time of the year in the UK, many people are suffering, as the temperatures and endless rain, alongside poorly constructed and/or ventilated homes, creates the perfect environment for damp, leaks and mould.
It’s only very recently that the health narrative has begun to shine a spotlight on mould, and those who have been suffering with no guidance for years are starting to realise that it’s actually the walls that house them that have been making them sick.
Mould is one of the oldest living species on earth. It’s natural, and it helps matter to decompose and produce nutrients, which is extremely useful, outside. Not all mould species are toxic, but many are and when mould starts to grow indoors, it gets comfortable and can quickly get out of control.
Due to the weather, old housing stock, poor building practices, inadequate insulation, a lack of damp proofing, and low awareness of the ongoing need for ventilation, we have a big problem with damp buildings in the UK. According to Shelter, there are 1 in 5 renters who are affected by damp and mould in Britain. And if you have a leak, it only takes 48 hours for damp building materials to grow mould. As a result, many of us are spending our days in mouldy homes or workplaces (not to mention mouldy vehicles)!
Mould from an infected building can readily infect the human body - which is a warm and damp environment that provides all the resources for the fungus to thrive. The illness that results is usually a combination of symptoms caused by exposure to fungal spores and exposure to mycotoxins. Mycotoxins are secondary metabolites produced by the mould, that are best understood as the weapons used by mould to defend itself and continue to grow.
The interesting thing about the illness is it can manifest in a number of different ways and people have varying levels of resilience to mould which means that you could be experiencing a lot of health issues while your partner is seemingly fine. However, mycotoxins will always be causing some level of damage, and they have the ability to cause damage to most systems in the body. They will likely reduce the immune system response, cause inflammation, oxidative and cellular damage, as well as attacking organs. Many mycotoxins are associated with neurological damage, kidney damage and a variety of cancers.
To add another slight complication, even if you no longer live or work in a mouldy environment, you could still be sick from the mould. This is largely based on the ability of fungus to form biofilms and communicate with other organisms in the body such as bacteria, and create destructive communication networks that work together to mediate symptoms. Also, there are a number of foods that are particularly prone to mould growth such as coffee, nuts, and grains (to name a few) that can exacerbate symptoms if your tolerance is low.
Common symptoms associated with mould illness:
Yes you can. In my clinic, I use a functional urine test in my clinic to detect mycotoxin metabolites from some of the most common mould species. Often a symptoms analysis and case history will give a very strong indication, but doing the testing is always best practice so that you know what you’re dealing with and the levels. There are some ways to test for mould in the home too at a range of expenses, including the use of damp meters and DIY mould test kits, to getting a professional company in.
You can also just look out for any of the following signs of mould growth in the home without testing but be mindful that mould can be hiding without a clear scent behind furniture, plaster, carpets and other building materials:
If you’re knowingly exposed to mould and are also symptomatic, the best possible course of action is to remove yourself from the environment for good, or use a company to professionally remediate. However, this can involve a great upheaval and expense, plus possibly knocking down and rebuilding parts of the building from scratch which means it’s sometimes not an immediate option.
Luckily, there are still many things that can be done to minimise exposure, even in an environment that’s prone to mould growth. First and foremost, minimising moisture build-up is crucial, which means maintaining adequate ventilation, and investing in a high-quality dehumidifier if you have an issue with damp. The simplest things to consider are keeping the windows open, heating the environment enough, and minimising excess moisture build up from showering, bathing and cooking through extractor fans, scraping the shower down after use, and so on.
Sometimes it’s going to be near enough impossible to get rid of all trace of mould (based on how clever and virulent it is) so in this case – so long as levels are manageable – you may want to invest in an air purifier. You want to look for one with a high clean air delivery rate (CADR) and as small a filter as possible (e.g. 99.9% / UltraHEPA) that has been tested for successful filtration of mycotoxins.
If you ever choose to clean the mould, never do it with bleach or harsh chemicals, as this will increase the amount of mycotoxins that are released into the air. There are a number of natural methods including the use of vinegar and essential oils, but always wear a mask and wash your clothes and shower immediately after cleaning so that you don’t carry spores around with you to other parts of the house.
If you have mould in your bedroom, then you might want to consider mouth taping at night using a produce such as the Dryft Sleep strips. There are a whole range of benefits from this practice, but within this context, your nose has a natural filtration system that can help to catch mould spores and mycotoxins in the nasal cavity and sinuses. You could then do a nasal rinse using a neti pot when you wake up in the morning to flush out anything from the sinuses and prevent the mould from getting deeper into the body where it can cause systemic damage.
Reducing your consumption of mouldy foods is also important. So make sure you’re aware of the key offenders, look out for mycotoxin-free products such as coffee brands, and you may even want to avoid medicinal mushrooms while you’re in the throes of tackling the mould issue as some people can’t tolerate any mushrooms either (case-dependant).
If you’re exposed to mould, or have symptoms from ongoing mould illness, then it’s important to encourage detoxification and elimination of the mycotoxins as much as possible. Make sure you’re exercising regularly and dry brushing with a brush like this one from Urban Veda or this from Higher Dose multiple times a week to keep the lymph flowing. The best practice to follow dry brushing is the sauna. This is a crucial part of healing from mould illness. If you don’t have access to a sauna, I recommend investing in a sauna blanket that you can use at home. If you’re encouraging faster detoxification, it’s also important to support the liver. This can be done through a range of supplements and consumption of nutrients. You could try taking beef liver capsules, while also taking a herbal product such as Quicksilver Scientific’s Liver Sauce to support phase 1 and 2. Some people also benefit from the use of castor oil packs for extra liver love.
Daily bowel movements are also critical to ensure that you are eliminating toxins and reducing the chances of them building up in the system. So if you struggle with constipation, there are a number of products you might want to try including. There are number of products to consider but the GI Fix from Artah might be a nice one to try because of the blend of gut-supporting pro kinetic plants and some probiotic strains. It can also be useful to take a biotoxin binder like this one from Quicksilver Scientific that can grab onto mycotoxins in the system and encourage them to pass out in the stool. However, make sure binders are taken away from food, medications and other supplements, and they should not be taken if you are constipated.
As mould drives oxidative damage, the consumption of antioxidants in the diet is critical - think vitamin C, spices and polyphenols - alongside possible supplementation for more enhanced support. While our body makes it’s own glutathione - the ‘master antioxidant’ - some people benefit from the acute use of liposomal glutathione while trying to heal from mould illness, particularly if chronic fatigue is one of their symptoms. Other people find that taking NAC and consuming enough glycine through protein and hydrolysed collagen is enough to support endogenous glutathione synthesis. For ease, companies such as Pure Encapsulations and Longevity Box have made combination products.
The final thing to consider is actually attempting to kill off the mould that might have bedded into your system with the use of a herbal antifungal protocol. However, this stage really has to be done with the support of a functional practitioner with experience in this area.
So as you can see, mould is a big topic. Each case tends to be complex and a little bit unique, and should always be tackled from a holistic perspective.
Written by Jade Leighton NT
This article is for informational purposes only, even if and regardless of whether it features the advice of physicians and medical practitioners. This article is not, nor is it intended to be, a substitute for professional medical advice, diagnosis, or treatment and should never be relied upon for specific medical advice. The views expressed in this article are the views of the expert and do not necessarily represent the views of Healf